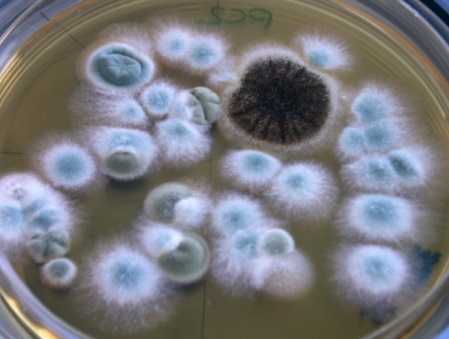
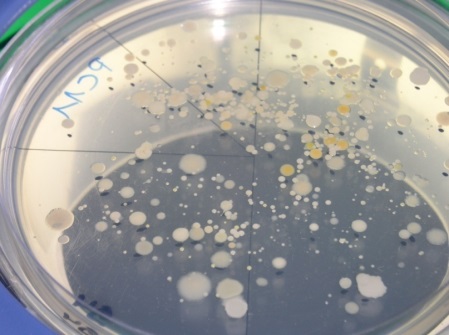

Prélèvement : Actif sur cassette
Analyse : comptage
Données de validation : Validation partielle
Substances
Informations générales
Propriétés physico-chimiques
| Nom | N° CAS | Formule chimique | Classification CMR |
|---|---|---|---|
| microorganismes aérobies |
|
Plus d'informations
| Nom | Masse molaire | Densité | Synonymes | Fiche toxicologique |
|---|---|---|---|---|
| microorganismes aérobies | Microorganismes du groupe pathogène 1 et 2;bactéries et moisissures hétérotrophes aérobies. |
Familles de substances
- AGENTS BIOLOGIQUES
- BIOAEROSOLS
Principe et informations
Ce protocole est destiné à l’analyse des microorganismes du groupe pathogène 1 et 2 tel que défini dans l’arrêté du 18 juillet 1994 fixant la liste des agents biologiques pathogènes, modifié par les arrêtés des 17 avril 1997 et 30 juin 1998. Il importe de respecter les recommandations concernant les règles d’hygiène et de sécurité pour la prévention des risques en général et notamment les risques biologiques. En particulier, les manipulations doivent être effectuées sous un poste de sécurité microbiologique et dans un laboratoire dont le niveau de confinement est suffisant et par du personnel qualifié.
Par ailleurs, toutes les manipulations doivent être effectuées avec du matériel stérile et en conditions aseptiques afin d’éviter les contaminations lors des analyses et dans le respect des normes relatives aux règles pour les examens microbiologiques et pour le mesurage des microorganismes dans l’air.
Principe de prélèvement et d'analyse
-
État physique
Particules en suspension (liquides ou/et solides) -
Type de prélèvements
Actif -
Nom du dispositif
cassette -
Technique analytique
COMPTAGE
Réactifs
- MILIEUX DE CULTURE GELOSES
- SOLUTION D'ELUTION
- TRYPTONE SEL
Méthode de prélèvement
Prélèvement des aérosols par cassette fermée
Un dispositif de prélèvement :
Dispositif N°1
-
Type dispositif
CASSETTE 37 mm 3 pièces -
Support ou substrat de collecte
- MEMBRANE POLYCARBONATE 0,8 µm
- TAMPON EN CELLULOSE
-
Commentaires, conseils et consignes

Conditions de prélèvement
-
Débit de prélèvement (L/min)
2
Pompe de prélèvement
- Pompe à débit de 1 à 5 L/min compensant les fortes pertes de charges (sup, à 20 pouces d'eau)
Conditionnement particulier
-
Choix conditionnement particulier
autre -
Description
Toutes les dispositions concernant l'assemblage et l'étanchéité des cassettes devront être vérifiées.
Les échantillons sont transportés le plus rapidement possible au laboratoire dans une enceinte réfrigérée à 4°C. Dans tous les cas, les échantillons doivent être analysés dans les 24 heures après le prélèvement.
Remarque : Le peu de données disponibles actuellement ne permet pas de mieux préciser les conditions de conservation des filtres après l'échantillonnage.
Préparation des dispositifs de prélèvement en vue d'une intervention en entreprise
Méthode d'analyse
Principe général de l'analyse en laboratoire
Préparation d'analyse
-
Durée de conservation prélèvements avant analyse
1 jour(s) -
Conditions de conservation avant analyse
4°C
-
Nombre d'étapes de préparation
4 -
Commentaires sur les étapes
La première étape consiste à extraire les microorganismes qui ont été collectés sur le filtre lors du prélèvement, ainsi que ceux qui ont pu se déposer sur les parois internes de la cassette, et de les remettre en suspension dans une solution aqueuse stérile. La seconde étape consiste à diluer la suspension obtenue. La troisième est l'étape d'étalement sur le milieu de culture et la dernière correspond à l'incubation.
4 étapes de préparation :
Étape de préparation N°1
-
Solvant ou solution
- SOLUTION STERILE (TWEEN 80 0.01% PEPTONE 0.1% EAU)
-
Type de préparation
Extraction -
Volume
10 mL -
Temps d'agitation
20 min -
Commentaires
- Retirer le bouchon d’entrée de la(es) cassette(s)
- Introduire 10 mL de solution d’élution dans chaque cassette.
- Remettre le bouchon d’entrée de la(es) cassette(s)
- Agiter la(es) cassette(s) pendant 20 minutes à 2000 rpm à l’aide d’un agitateur à rotation orbitale.
- Récupérer la suspension puis la transférer dans les tubes stériles pour analyse.
- Cette suspension constitue la suspension mère à analyser.
Pour les prélèvements conduisant à une collecte des particules aéroportées dans un liquide, le liquide de collecte constitue la suspension mère à analyser dont il faut définir ou ajuster le volume.
Étape de préparation N°2
-
Solvant ou solution
- SOLUTION PHYSIOLOGIQUE (TYPE TRYPTONE DE SEL TS)
-
Type de préparation
Dilution -
Volume
9 mL -
Commentaires
- La suspension mère est diluée successivement dans une solution physiologique stérile, par exemple de tryptone sel (TS).
- La dilution décimale en cascade est effectuée en transférant une prise d’essai de 1 mL de suspension à diluer dans un tube contenant 9 ml de TS.
- Pour les dilutions autres que la dilution décimale, la quantité de TS est ajustée à la prise d’essai.
- Le nombre de dilutions nécessaires est choisi en fonction de la concentration attendue en microorganismes dans la suspension.

Dilution en série de l’échantillon dans une solution physiologique:
agitation au vortex
Étape de préparation N°3
-
Type de préparation
Etalement -
Commentaires
Etalement de la suspension à analyser sur le milieu de culture :
- Déposer 0,1 mL de la suspension à analyser (suspension mère et/ou l’une des dilutions) sur le milieu de culture
- Etaler de façon uniforme à l’aide d’un étaleur stérile jusqu’à ce qu’il ne reste plus de liquide visible à la surface du milieu.
- Chaque dilution est étalée sur deux boites de milieu et pour au moins trois dilutions successives.
- Etalement de la suspension diluée sur les milieux de culture

Étape de préparation N°4
-
Type de préparation
Incubation -
Commentaires
- Les boites de Pétri contenant les milieux de culture ensemencés sont disposées (en position retournées) dans un incubateur par piles d’un maximum de 6.
- L’incubation des boites de Pétri est effectuée dans les conditions appropriées. Les conditions d’incubation (température de consigne (TC°C) ; humidité relative de l’air ; durée d’incubation) sont définies en fonction des exigences des microorganismes recherchés (cf annexe I dans les données de validations complémentaires).
- L’incubateur est réglé sur la température de consigne (TC°C) +/-2°C désirée.
- Un récipient contenant de l’eau est placé dans l’incubateur de manière à maintenir dans l’enceinte une humidité relative élevée. L’incubateur peut être réfrigéré et programmable.
Une condition analytique :
Condition analytique N°1
-
Technique analytique
- COMPTAGE
-
Commentaires, conseils ou condition particulières
- Les colonies ou UFC (Unités Formant Colonies) qui se sont développées à la surface du milieu de culture sont comptées, si possible, tous les jours et sur toute la durée de l’incubation (photos 1 et 2).
- Le comptage est effectué visuellement à l’aide éventuellement d’une loupe pour les boites contenant entre 0 et 300 colonies visibles.
- Selon le milieu de culture et les conditions d’incubation choisis, les colonies bactériennes et les colonies fongiques peuvent être distinguées.
- En fonction des objectifs de la mesure, une identification des colonies peut être nécessaire. Cette identification peut être effectuée après repiquage par des méthodes phénotypiques, biochimiques ou moléculaires.
- Les résultats de dénombrement sont consignés pour exploitation ultérieure.
- Les résultats provenant des boites présentant plus de 300 colonies visibles à la surface du milieu de culture après incubation sont consignés avec une mention spéciale (par exemple « >300 »).
Moisissures développées sur milieu MEA après incubation :
Bactéries développées sur milieu TSA après incubation :
Notes:
- Les échantillons peuvent être conservés au réfrigérateur à 4°C dans l’attente d’une ré-analyse ultérieure.
- Les déchets doivent être traités par la filière des déchets d'activités de soins à risques infectieux (DASRI).
Étalonnage et expression des résultats
La méthode d'étalonnage indiquée est celle utilisée lors du développement. Elle n'a cependant pas de caractère obligatoire
-
Calcul de la quantité de substance sur le dispositif
EXPRESSION DES RÉSULTATS
Cas général : entre 15 à 300 colonies visibles à la surface du milieu de culture
Le cas général s’applique lorsque au moins une boite de Pétri présente au minimum 15 colonies visibles à la surface du milieu de culture après incubation.
- Sélectionner les boites de Pétri exploitables pour le calcul. Ces boites correspondent à celles provenant de deux dilutions successives et dont au moins une boîte présente au minimum 15 colonies visibles à la surface du milieu de culture après incubation (soit au maximum 4 boites). Les boites présentant plus de 300 colonies visibles à la surface du milieu de culture après incubation ne sont pas exploitables.
- Calculer le nombre « C » d’UFC (Unités Formant Colonies) sur les boites exploitables correspondantes à l’aide de la formule suivante :

Avec :
: somme des colonies comptées sur l’ensemble des boîtes de Pétri sélectionnées et exploitables (boites provenant de deux dilutions successives et dont au moins une contient 15 colonies ; seules les boites correspondant à un nombre d’UFC inférieur ou égal à 300 sont considérées dans le calcul).- Calculer la concentration « Np » (UFC/mL) en microorganismes cultivables dans la prise d’essai de l’échantillon à l’aide de la formule suivante :

Avec :
C : nombre d’UFC (unités formant colonies) observées sur l’ensemble des boites sélectionnées et exploitables (boites provenant de deux dilutions successives et dont au moins une contient 15 colonies ; seules les boites correspondant à un nombre d’UFC inférieur ou égal à 300 sont considérées dans le calcul)
v : volume de la suspension étalée à la surface des milieux en mL (par exemple 0,1 mL).
n1 : nombre de boîtes retenues à la première dilution (la plus faible).
n2 : nombre de boîtes retenues à la seconde dilution (la plus forte)
d : taux de dilution correspondant à la dilution la plus faible retenue (d = 1 pour l’échantillon non dilué ; d = 0,01 pour la dilution au 1/100ième etc…).
- Les résultats sont arrondis à deux chiffres significatifs après la virgule et sont exprimés en UFC par mL dans la suspension cellulaire d’origine.

Estimation des petits nombres : de 1 à 14 colonies visibles à la surface du milieu de culture
Le cas de l’estimation des petits nombres s’applique lorsque aucune des boites de Pétri ne présente plus de 14 colonies visibles à la surface du milieu de culture après incubation.
- Sélectionner les boites de Pétri provenant d’une seule et même dilution contenant le plus d’UFC parmi toutes les boites disponibles. Aucune des boites disponibles ne doit présenter un nombre de colonies visibles à la surface du milieu de culture après incubation supérieur ou égal à 15.
- Calculer le nombre « C » d’UFC (unités formant colonies) sur les boites sélectionnées et exploitables à l’aide de la formule suivante :

Avec :
: somme des colonies comptées sur les boîtes de Pétri sélectionnées et exploitables (boites provenant de l’étalement d’une seule et même dilution et présentant un nombre d’UFC strictement inférieur à 15).- Calculer la concentration « Np » (UFC/mL) en microorganismes cultivables dans la prise d’essai de l’échantillon à l’aide de la formule suivante :

Avec :
N : nombre d’UFC (unités formant colonies) observées sur l’ensemble des boites sélectionnées
v : volume de la suspension étalée à la surface des milieux en mL
n : nombre de boîtes exploitables (1 ou 2 dans ce cas)
d : taux de dilution de la suspension étalée sur les boites de Pétri retenues pour le calcul. (d = 1 pour l’échantillon non dilué ; d = 0,01 pour la dilution au 1/100ième etc…).

Aucune colonie visible à la surface du milieu de culture
Si aucune des boîtes Pétri ne présente au moins 1 colonie microbienne visible à la surface du milieu de culture après incubation le résultat doit être exprimé de la manière suivante :
- Cp = inférieure à la limite de détection de la méthode (1 UFC/mL).
Historique
| Version | Date | Modification(s) faisant l’objet de la nouvelle version | Paragraphes concernés |
|---|---|---|---|
| 121/V01.01 | 31/03/2014 | Création. |
|
| Microorganismes aérobies M-147 | Novembre 2015 | Mise en ligne |
|
Date de mise à jour : novembre 2015
Ancien numéro de fiche MétroPol : 121